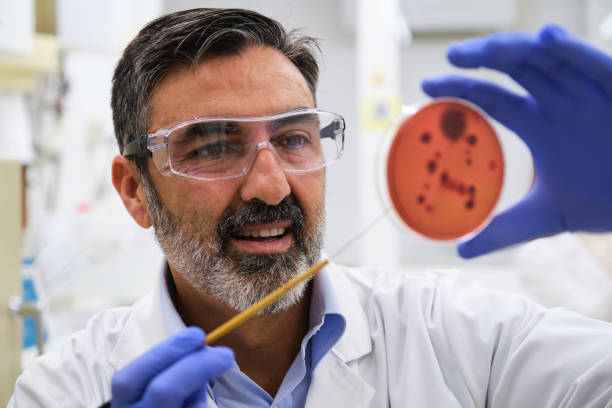
Senior Microbiologist/Research Lead

Overview
A Microbiologist is a specialized scientist who studies microorganisms such as bacteria, viruses, fungi, and algae, focusing on their structure, function, and interactions with other organisms and environments. They work in research institutions, healthcare facilities, universities, pharmaceutical industries, and environmental agencies. Microbiologists apply biological, chemical, and molecular techniques to understand microbial behavior, develop medical treatments, and address environmental challenges, contributing to fields like medicine, agriculture, and biotechnology. Combining expertise in biology, biochemistry, and genetics, they play a crucial role in advancing public health, food safety, and scientific innovation in a world where microorganisms impact every aspect of life, from disease prevention to industrial processes.
Microbiologists are experts who focus on the study of microorganisms, their roles in ecosystems, and their applications to solve problems related to health, agriculture, and environmental sustainability. Their work involves analyzing microbial samples in laboratories, conducting field studies, and applying findings to industries like healthcare, food production, and bioprocessing. They often operate in academic, governmental, or industrial settings, balancing technical research with practical applications and interdisciplinary collaboration. Microbiologists are essential to fields like infectious disease control, biotechnology, and environmental protection, serving as experts in microbial science, contributing to solutions for global health challenges, advancing technological innovations, and protecting scientific integrity, addressing pressing global issues through rigorous research, and improving outcomes through evidence-based strategies in a scientific landscape where microbiology’s relevance continues to grow due to emerging diseases and biotechnological needs.
Roles and Responsibilities
Roles and Responsibilities:
- Microbial Analysis and Identification
- Analyze microbial samples using techniques like microscopy, culturing, and molecular sequencing to identify species and characteristics.
- Study microbial growth, metabolism, and genetic properties for scientific and applied purposes.
- Disease Research and Control
- Investigate pathogens to understand disease mechanisms and develop diagnostic tools or treatments.
- Collaborate with healthcare providers to monitor and control infectious disease outbreaks.
- Environmental Microbiology
- Study microorganisms in soil, water, and air to assess environmental health and pollution levels.
- Develop bioremediation strategies to clean up contaminated sites using microbes.
- Biotechnology and Product Development
- Utilize microorganisms to produce antibiotics, vaccines, enzymes, and other bioproducts.
- Engineer microbes for industrial applications like biofuel production or waste treatment.
- Food Safety and Quality
- Test food and water samples for microbial contamination to ensure public safety.
- Develop preservation techniques to prevent spoilage and foodborne illnesses.
- Public Health Monitoring
- Monitor microbial resistance to antibiotics and advise on strategies to combat superbugs.
- Support vaccination programs by studying immune responses to pathogens.
- Genetic and Molecular Research
- Conduct experiments on microbial DNA and RNA to understand evolutionary relationships and functions.
- Use genetic engineering to modify microbes for research or industrial purposes.
- Education and Outreach
- Teach courses on microbiology, infectious diseases, or biotechnology in academic institutions.
- Educate communities and policymakers on microbial risks and prevention strategies.
- Policy and Regulation
- Advise on regulations related to biosafety, food safety, and environmental protection.
- Contribute to guidelines for handling and containing hazardous microorganisms.
- Interdisciplinary Collaboration
- Work with biochemists, epidemiologists, and engineers to integrate microbiological data into broader projects.
- Collaborate with industry to apply research in practical contexts like drug development or agriculture.
Study Route & Eligibility Criteria:
| Route | Steps |
| Route 1 | 1. 10+2 with Physics, Chemistry, and Biology (PCB). 2. Bachelor’s degree in Microbiology, Biotechnology, or Life Sciences (3-4 years). 3. Master’s degree in Microbiology or Applied Microbiology (2 years). 4. PhD in Microbiology or related field (3-5 years, optional). 5. Postdoctoral research or lab experience in microbial science (optional). |
| Route 2 | 1. 10+2 with Physics, Chemistry, and Biology (PCB). 2. Bachelor’s degree in Biology or Biochemistry (3-4 years). 3. Master’s degree in Microbiology or Biotechnology (2 years). 4. Specialized training in microbial techniques (6 months-1 year). 5. Practical experience in microbiology labs or field studies. |
| Route 3 | 1. 10+2 with Physics, Chemistry, and Biology (PCB). 2. Bachelor’s degree in Environmental Science or Biomedical Sciences (3-4 years). 3. Master’s degree in Microbiology or Environmental Microbiology (2 years). 4. Internship or fellowship in microbiology research labs (1-2 years). 5. Certification in advanced microbial analysis techniques (optional). |
| Route 4 | 1. 10+2 with Physics, Chemistry, and Biology (PCB). 2. Bachelor’s degree from India in relevant field (3-4 years). 3. Master’s or PhD in Microbiology abroad (2-5 years). 4. Training or postdoctoral research in international microbiology programs (1-3 years). 5. Certification or licensure for international practice (if applicable). |
Significant Observations (Academic Related Points):
- Competitive Entrance Examinations: Clearing university-specific entrance tests for Bachelor’s and Master’s programs or national-level exams for research fellowships in India and abroad is critical for entry into relevant programs.
- Variable Academic Commitment: Requires a journey of 5-10 years post-high school for most roles, with additional years for PhD or postdoctoral research in Microbiology.
- Strong Foundation in Core Subjects: Academic excellence in subjects like Biology, Chemistry, and Biochemistry during undergraduate studies is essential for understanding microbial systems.
- Practical Performance: Hands-on training during Master’s or PhD programs in lab techniques and microbial culturing is crucial for securing competitive positions in Microbiology.
- Research and Publications: Engaging in microbiological research projects and publishing findings during academic or professional programs can enhance prospects for academic and industry roles.
- Fellowship Selection: Securing research fellowships or grants often requires a strong academic record, practical skills, and relevant project experience in microbial studies.
- Continuous Education: Mandatory participation in workshops, seminars, and short courses to stay updated with evolving microbial analysis and biotechnological techniques.
- Specialization Certification: Obtaining certifications in niche areas like clinical microbiology or industrial microbiology can provide a competitive edge in the field.
- Subspecialty Training: Pursuing additional training in areas like virology or microbial genetics can enhance career prospects.
- Language Proficiency for International Practice: Clearing language proficiency tests like IELTS or TOEFL with high scores is often necessary for pursuing opportunities abroad.
Internships & Practical Exposure:
- Lab internships in microbiology focusing on microbial culturing and molecular analysis.
- Research apprenticeships with health organizations for infectious disease studies.
- Observerships in clinical labs studying pathogen identification and antibiotic resistance.
- Participation in environmental projects assessing microbial impacts on ecosystems.
- Training in advanced microbial sequencing technologies under supervision.
- Experience in pharmaceutical companies applying microbiology to drug development.
- Involvement in data collection for food safety and water quality studies.
- Attendance at microbiology or biotechnology conferences and workshops.
- Exposure to interdisciplinary projects with biochemists or epidemiologists.
- Collaborative research in international microbiology labs for global exposure.
Courses & Specializations to Enter the Field:
- Bachelor’s in Microbiology, Biotechnology, or Life Sciences.
- Bachelor’s in Biology or Biochemistry.
- Master’s in Microbiology or Applied Microbiology.
- PhD in Microbiology or Microbial Genetics.
- Certification courses in Clinical Microbiology and Biosafety.
- Training in Environmental Microbiology and Bioremediation.
- Specialized courses in Industrial Microbiology.
- Master’s in Biotechnology with Microbiology focus.
- Continuing Education courses in Virology and Immunology.
- Short-term courses in Microbial Genomics and Proteomics.
Top Institutes for Microbiologist Education (India):
| Institute | Course/Program | Official Link |
| Indian Institute of Science (IISc), Bangalore | MSc/PhD in Biological Sciences | https://www.iisc.ac.in/ |
| Jawaharlal Nehru University (JNU), New Delhi | MSc/PhD in Life Sciences | https://www.jnu.ac.in/ |
| University of Delhi, Delhi | MSc/PhD in Microbiology | https://www.du.ac.in/ |
| Banaras Hindu University (BHU), Varanasi | MSc/PhD in Microbiology | https://www.bhu.ac.in/ |
| Indian Institute of Technology (IIT), Kharagpur | MSc/PhD in Biotechnology | https://www.iitkgp.ac.in/ |
| University of Calcutta, Kolkata | MSc/PhD in Microbiology | https://www.caluniv.ac.in/ |
| Savitribai Phule Pune University, Pune | MSc/PhD in Microbiology | https://www.unipune.ac.in/ |
| Anna University, Chennai | MSc/PhD in Biotechnology | https://www.annauniv.edu/ |
| University of Hyderabad, Hyderabad | MSc/PhD in Biotechnology | https://www.uohyd.ac.in/ |
| Institute of Microbial Technology (IMTECH), Chandigarh | MSc/PhD in Microbial Biotechnology | https://www.imtech.res.in/ |
Top International Institutes:
| Institution | Course | Country | Official Link |
| Massachusetts Institute of Technology (MIT) | MSc/PhD in Biology | USA | https://www.mit.edu/ |
| University of California, Berkeley | MSc/PhD in Microbiology | USA | https://www.berkeley.edu/ |
| University of Oxford | DPhil in Biochemistry | UK | https://www.ox.ac.uk/ |
| University of Queensland | MSc/PhD in Biotechnology | Australia | https://www.uq.edu.au/ |
| ETH Zurich | MSc/PhD in Biosciences | Switzerland | https://www.ethz.ch/ |
| University of Toronto | MSc/PhD in Molecular Genetics | Canada | https://www.utoronto.ca/ |
| Imperial College London | MSc/PhD in Life Sciences | UK | https://www.imperial.ac.uk/ |
| California Institute of Technology (Caltech) | MSc/PhD in Biology and Biological Engineering | USA | https://www.caltech.edu/ |
| University of Western Australia | MSc/PhD in Microbiology | Australia | https://www.uwa.edu.au/ |
| University of Cambridge | PhD in Biological Sciences | UK | https://www.cam.ac.uk/ |
Entrance Tests Required:
India:
- Graduate Aptitude Test in Engineering (GATE) for Master’s programs in Biotechnology at IITs and other institutes.
- Council of Scientific and Industrial Research (CSIR) NET for research fellowships and PhD programs.
- University-specific entrance exams for Master’s and PhD programs in Microbiology (e.g., JNU CEEB, DUET).
- State-level entrance examinations for postgraduate programs in Life Sciences.
- Indian Institute of Science Entrance Test (IISc) for research programs.
International:
- Graduate Record Examination (GRE) for postgraduate programs in Biological Sciences in the USA and Canada.
- International English Language Testing System (IELTS) with a minimum score of 6.5-7.0 for international programs.
- Test of English as a Foreign Language (TOEFL) with a minimum score of 90-100 for programs in English-speaking countries.
- University-specific entrance exams for international Master’s or PhD programs in related fields.
- Australian Education Assessment Services for programs in Australia.
- Specific fellowship or scholarship exams for international research opportunities.
Ideal Progressing Career Path
Undergraduate Student → Graduate Trainee (Master’s) → Junior Microbiologist → Established Microbiologist → Senior Microbiologist/Research Lead → Program Director/Professor
Major Areas of Employment:
- Academic institutions conducting research and teaching in microbiology and life sciences.
- Healthcare facilities diagnosing and managing infectious diseases.
- Pharmaceutical industries developing drugs and vaccines.
- Environmental agencies monitoring microbial impacts on ecosystems.
- Government bodies overseeing public health and biosafety policies.
- Research institutions studying microbial genetics and biotechnology.
- Food and beverage industries ensuring product safety and quality.
- International collaborations addressing global health and environmental challenges.
- Biotechnology firms engineering microbes for industrial applications.
- Agricultural sectors improving crop health through microbial solutions.
Prominent Employers:
| India | International |
| Indian Council of Medical Research (ICMR) | Centers for Disease Control and Prevention (CDC), USA |
| Council of Scientific and Industrial Research (CSIR) | World Health Organization (WHO) |
| National Institute of Virology (NIV), Pune | National Institutes of Health (NIH), USA |
| Department of Biotechnology (DBT), Government of India | European Centre for Disease Prevention and Control (ECDC) |
| Institute of Microbial Technology (IMTECH), Chandigarh | Public Health England (PHE), UK |
| All India Institute of Medical Sciences (AIIMS) | Pfizer (Pharmaceutical Company), USA |
| National Centre for Disease Control (NCDC) | Novartis (Pharmaceutical Company), Switzerland |
| Bharat Biotech International Limited | GlaxoSmithKline (GSK), UK |
| Serum Institute of India | International Society for Microbiology (ISM) |
| Dr. Reddy’s Laboratories | Bill & Melinda Gates Foundation (Global Health Programs) |
Pros and Cons of the Profession:
| Pros | Cons |
| Significant contribution to public health and sustainability through microbial research. | Requires continuous learning to keep up with rapidly evolving microbial technologies and resistance patterns. |
| Intellectually stimulating work combining biology, chemistry, and genetics in microbiological analysis. | Competitive field for academic and industry positions, often requiring extensive lab work and publications. |
| High impact on global health by contributing to disease prevention and biotechnological innovations. | Lab-intensive role with potential exposure to hazardous pathogens or biohazards. |
| Opportunities for innovation in vaccine development, bioremediation, and industrial microbiology. | Limited public awareness of microbiology as a career, leading to fewer mainstream opportunities in some regions. |
| Growing relevance due to increasing concerns over emerging diseases, antibiotic resistance, and environmental challenges. | Funding constraints for research projects can limit scope and career progression in academia or applied fields. |
Industry Trends and Future Outlook:
- Antimicrobial Resistance: Increasing focus on studying and combating antibiotic-resistant microbes through novel therapies.
- Vaccine Development: Growing demand for microbiologists in developing vaccines for emerging and re-emerging diseases.
- Digital Data Integration: Enhanced use of bioinformatics and AI for analyzing microbial genomes and predicting outbreaks.
- Synthetic Biology: Rising interest in engineering microbes for sustainable solutions in energy and waste management.
- Interdisciplinary Applications: Greater emphasis on combining microbiology with public health and environmental science for broader insights.
- Automation in Diagnostics: Increased adoption of automated systems for rapid microbial identification and testing.
- Microbiome Research: Development of studies on human and environmental microbiomes for health and ecological benefits.
- Global Health Security: Growing role of microbiological research in addressing pandemics and bioterrorism threats.
- Citizen Science Initiatives: Expansion of community involvement in microbial monitoring and health awareness.
- Policy and Advocacy: Increasing influence of microbiologists in shaping biosafety and public health policies.
Salary Expectations:
| Career Level | India (₹ per annum) | International (US$ per annum) |
| Trainee/Graduate Student | 2,00,000 - 4,00,000 | $20,000 - $30,000 |
| Junior Microbiologist | 4,00,000 - 7,00,000 | $35,000 - $50,000 |
| Established Microbiologist | 7,00,000 - 12,00,000 | $50,000 - $70,000 |
| Senior Microbiologist/Research Lead | 12,00,000 - 20,00,000 | $70,000 - $90,000 |
| Program Director/Professor | 20,00,000 - 35,00,000 | $90,000 - $130,000 |
Key Software Tools:
- Bioinformatics Tools: Software like BLAST and MEGA for analyzing microbial DNA and RNA sequences.
- Laboratory Information Management Systems (LIMS): Platforms for managing microbial sample data and lab workflows.
- Statistical Analysis Tools: Software like R and SPSS for processing large datasets from microbiological research.
- Genomic Sequencing Software: Tools such as Illumina BaseSpace for interpreting microbial genome data.
- Microbial Imaging Software: Programs like ImageJ for analyzing microscopic images of microorganisms.
- Data Visualization Tools: Software like Tableau or MATLAB for presenting microbiological data graphically.
- Molecular Modeling Software: Tools such as PyMOL for studying microbial protein structures.
- Database Management Platforms: For organizing extensive records of microbial strains and experimental data.
- Field Data Collection Apps: Mobile tools for real-time data entry during environmental microbial surveys.
- Collaboration Platforms: For interdisciplinary teamwork and data sharing with biologists and public health experts.
Professional Organizations and Networks:
- International Society for Microbiology (ISM)
- American Society for Microbiology (ASM)
- Society for General Microbiology (SGM), UK
- Indian Association of Microbiologists (IAM)
- Federation of European Microbiological Societies (FEMS)
- International Union of Microbiological Societies (IUMS)
- Indian Society for Medical Microbiology (ISMM)
- Asia-Pacific Society for Microbiology (APSM)
- World Federation for Culture Collections (WFCC)
- Biotechnology Industry Organization (BIO)
Notable Microbiologists and Industry Leaders (Top 10):
- Dr. Louis Pasteur (Historical, France): Renowned for foundational work in microbiology, including pasteurization and vaccine development, active from the 1850s to 1890s.
- Dr. Robert Koch (Historical, Germany): Known for identifying the causative agents of tuberculosis, cholera, and anthrax, active from the 1870s to 1910s.
- Dr. Alexander Fleming (Historical, UK): Noted for discovering penicillin, the first antibiotic, active from the 1920s to 1950s at St. Mary’s Hospital, London.
- Dr. Selman Waksman (Historical, USA): Recognized for discovering streptomycin and advancing antibiotic research, active from the 1930s to 1970s at Rutgers University.
- Dr. Rita Colwell (Contemporary, USA): Known for research on cholera and environmental microbiology, active since the 1960s at the University of Maryland.
- Dr. Stanley B. Prusiner (Contemporary, USA): Noted for discovering prions, a novel infectious agent, active since the 1970s at the University of California, San Francisco.
- Dr. Ananda Mohan Chakrabarty (Contemporary, India/USA): Recognized for developing a genetically engineered microbe for oil spill cleanup, active since the 1970s at the University of Illinois.
- Dr. Bonnie Bassler (Contemporary, USA): Known for work on bacterial quorum sensing and communication, active since the 1990s at Princeton University.
- Dr. Renu Swarup (Contemporary, India): Noted for contributions to biotechnology and microbial research policy, active since the 1980s, former Secretary of the Department of Biotechnology, India.
- Dr. Jennifer Doudna (Contemporary, USA): Recognized for co-developing CRISPR-Cas9 gene editing technology with microbial origins, active since the 1990s at the University of California, Berkeley.
Advice for Aspiring Microbiologists:
- Build a strong foundation in biology, chemistry, and biochemistry during undergraduate studies to prepare for specialized learning.
- Seek early exposure through internships or lab work in microbiology to gain practical experience in culturing and analysis.
- Develop technical skills in microbial genomics, bioinformatics, and lab techniques during Master’s or PhD programs for a competitive edge.
- Engage in interdisciplinary learning by exploring biotechnology, public health, and environmental science alongside microbiology.
- Pursue research opportunities or fellowships to deepen expertise in niche areas like virology or industrial microbiology.
- Cultivate mentoring relationships with established microbiologists for career guidance and networking opportunities.
- Stay updated with advancements in microbial technologies, antibiotic resistance research, and biotechnological applications.
- Publish research findings or case studies in scientific journals to establish credibility and contribute to the field.
- Consider international exposure through collaborative projects, conferences, or advanced research abroad to broaden perspectives.
- Balance technical expertise with practical applications to address real-world challenges like disease outbreaks and environmental sustainability.
A career as a Microbiologist offers a unique opportunity to impact public health, environmental sustainability, and industrial innovation by studying the intricate world of microorganisms. From conducting detailed laboratory research to developing solutions for global health crises, Microbiologists play a pivotal role in addressing some of the world’s most pressing challenges related to infectious diseases, food safety, and biotechnological advancement. This field combines rigorous scientific inquiry, technological innovation, and interdisciplinary collaboration, offering diverse paths in academia, industry, and public health. For those passionate about biological sciences, health protection, and scientific discovery, a career as a Microbiologist provides a deeply rewarding journey with significant potential for making meaningful contributions to society in an era where microbial research continues to shape global health, sustainability, and technological priorities.